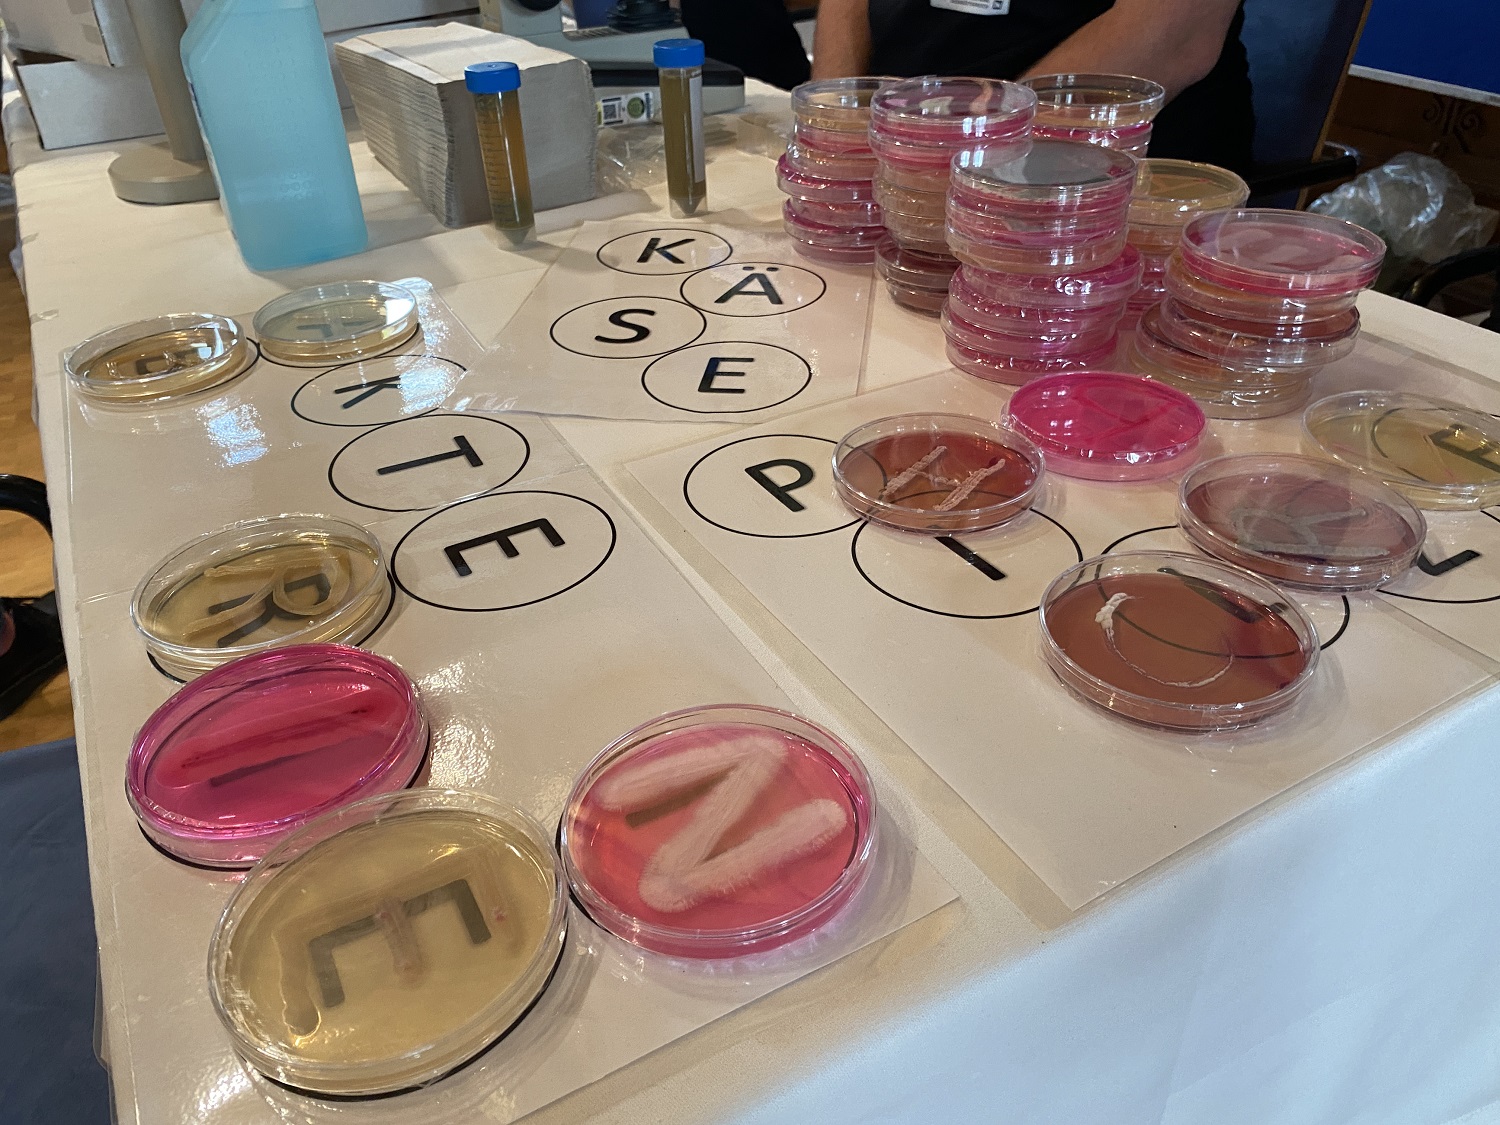
IMG_7758.JPG

NÖ Forschungsfest 2022
Wer sind die wahren Helden der Käseproduktion? Am NÖ Forschungsfest 2022 gab’s bei FFoQSI Forschung zum Angreifen – und schmecken!
09/2022. A taste of Science!
Am Freitag, den 22. September 2022 öffnete das Palais Niederösterreich in der Herrengasse 13 in der Wiener Innenstadt seine Tore für die Wissenschaftler:innen von Morgen. Über 70 Forschungstationen boten den jungen Besucher:innen hochtechnologische und komplexe Forschung zum Bestaunen, Ausprobieren und Angreifen.
Als wahres Besucher:innen-Magnet präsentierte sich der FFoQSI Stand. Mag. Viktoria Neubauer, PhD, wissenschaftliche Leiterin der FFoQSI Postharvest-Forschungsarea vermittelte zusammen mit ihrem engagiertes Team die komplexen Schritte der Käseproduktion auf spielerische Art und Weise – von Kuhfutter zum Riechen und Anfassen bis hin zum Legespiel mit echten Bakterienkulturen. Ein Standkonzept, dass sogar Landeshauptfrau Johanna Mikl-Leitner begeistern konnte!
Wie das Ergebnis der erforschten Produktionsschritte am Ende schmeckt? Das durften große und kleine Besucher:innen bei der abschließenden Verkostung von Käsesorten unterschiedlichen Reifegrades erfahren!